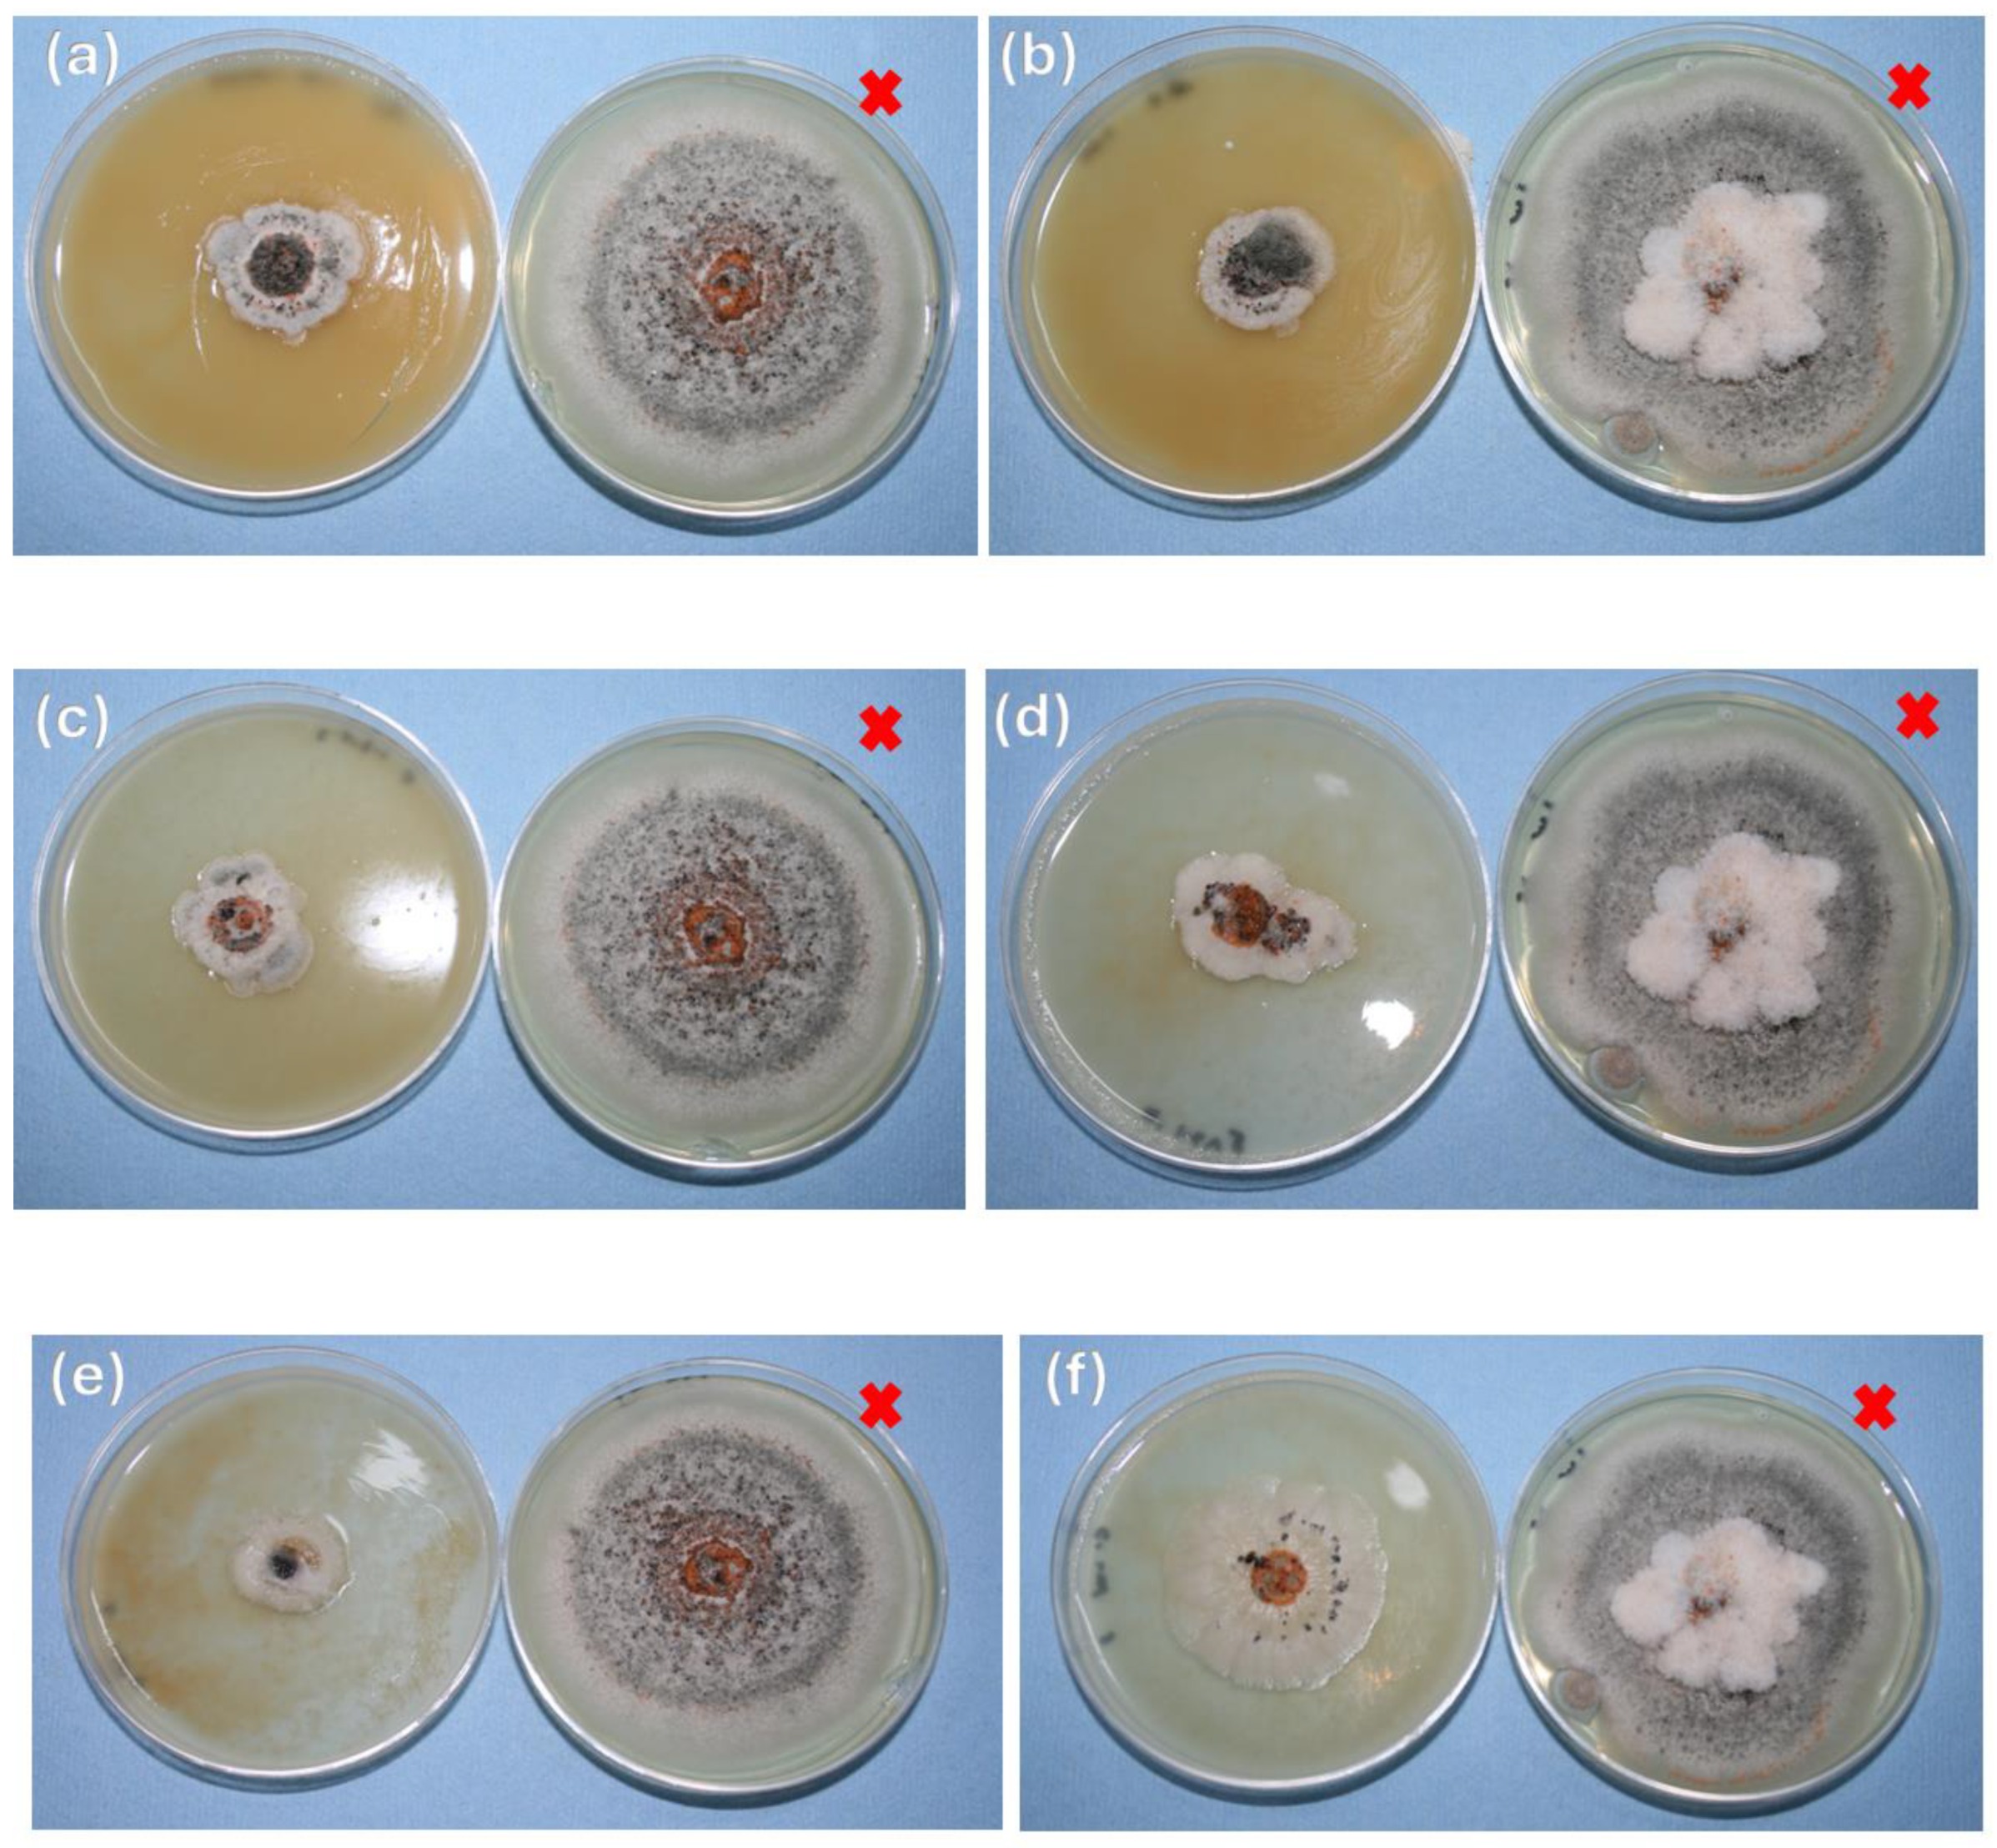
Polymers 16 03058 g006

Ultrasonic Production of Chitosan Nanoparticles and Their Application Against Colletotrichum gloeosporioides Present in the Ataulfo Mango
Abstract
1. Introduction
2. Materials and Methods
2.1. Materials
2.2. Preparation of Chitosan Nanoparticles
2.3. Characterizations
2.3.1. Scanning Electron Microscopy (SEM)
2.3.2. Fourier-Transform Infrared Spectroscopy (FTIR)
2.3.3. Atomic Force Microscopy, AFM
2.4. Antifungal Activity
2.4.1. Isolation of the Fungus Colletotrichum Gloeosporioides
2.4.2. Characterization of Colletotrichum Gloeosporioides
2.4.3. In Vitro Assays
2.4.4. Fungus Growth
2.5. Statistic Analysis
3. Results and Discussion
3.1. Infrared Spectroscopy
3.2. Scanning Electron Microscopy
3.3. Atomic Force Microscopy
3.4. Identification of Colletotrichum Gloeosporioides
3.5. In Vitro Assays
3.6. Statistical Analysis
4. Conclusions
Author Contributions
Funding
Data Availability Statement
Acknowledgments
Conflicts of Interest
References
- Castro, V.M.R.; Ortega, A.C.B.; Lagarda, J.L.V.; López, A.M.; Paredes, J.M.M. Cambios Fisicoquímicos Durante Maduración en Condiciones Locales de Venta de Frutos de Mango Ataulfo de San Marcos Guerrero, Mex. 2022. Available online: https://quimicahoy.uanl.mx/index.php/r/article/view/277 (accessed on 11 July 2024).
- Mendoza-Hernández, C.; Rosas-Quijano, R.; Vázquez-Ovando, A.; Gálvez-López, D. Retos y controversias del mango Ataulfo. Rev. Mex. Cienc. Agric. 2020, 11, 1633–1645. [Google Scholar] [CrossRef]
- Secretaria de Agricultura y Desarrollo Rural. Produccion de Mango Ataulfo. Available online: https://www.gob.mx/agricultura/articulos/el-mango-producto-estrella-en-mexico (accessed on 20 August 2024).
- Monteon-Ojeda, A.; Pérez-Rodríguez, A.; Mora-Aguilera, J.A.; Sandoval-Islas, J.S.; De-León-García-De-Alba, C.; Hernández-Castro, E.; Vásquez-López, A. Evaluation of tolerance to vegetative antracnosis of new mango germplasms in Mexico. Trop. Subtrop. Agroecosyst. 2017, 20, 447–456. [Google Scholar] [CrossRef]
- Noriega-Cantú, D.H.; Pereyda-Hernández, J.; Garrido-Ramírez, E.R.; Noriega-Cantú, D.H.; Pereyda-Hernández, J.; Garrido-Ramírez, E.R. Efecto de factores climatológicos sobre la fluctuación de esporas en árboles de mango cv. Ataulfo en Guerrero, México. Rev. Mex. Fitopatol. 2017, 35, 227–241. [Google Scholar] [CrossRef]
- Noriega-Cantú, D.H.; Martinez-Bolaños, M.; Garrido-Ramírez, E.R.; Palacio-Martinez, V.; Ariza-Flores, R. Antracnosis del mango: Tecnología de manejo integrado. AGRICULTURA-INIFAP–CIRPAS. Campo Experimental Iguala. Libro Técnico Núm. 6. Iguala de la Independencia, Guerrero, México. 2024; Available online: https://www.researchgate.net/publication/381519164_ANTRACNOSIS_DEL_MANGO_TECNOLOGIA_DE_MANEJO_INTEGRADO_ANTRACNOSIS_DEL_MANGO_TECNOLOGIA_DE_MANEJO_INTEGRADO (accessed on 20 August 2024).
- Khezerlou, A.; Alizadeh-Sani, M.; Azizi-Lalabadi, M.; Ehsani, A. Nanoparticles and their antimicrobial properties against pathogens including bacteria, fungi, parasites and viruses. Microb. Pathog. 2018, 123, 505–526. [Google Scholar] [CrossRef] [PubMed]
- Maluin, F.N.; Hussein, M.Z. Chitosan-Based Agronanochemicals as a Sustainable Alternative in Crop Protection. Molecules 2020, 25, 1611. [Google Scholar] [CrossRef]
- Malerba, M.; Cerana, R. Recent Advances of Chitosan Applications in Plants. Polymers 2018, 10, 118. [Google Scholar] [CrossRef]
- Oh, J.W.; Chun, S.C.; Chandrasekaran, M. Preparation and In Vitro Characterization of Chitosan Nanoparticles and Their Broad-Spectrum Antifungal Action Compared to Antibacterial Activities against Phytopathogens of Tomato. Agronomy 2019, 9, 21. [Google Scholar] [CrossRef]
- Costantini, R.; Ventura-Aguilar, R.I.; Hernández-López, M.; Bautista-Baños, S.; Barrera-Necha, L.L. Potencial antifúngico de nanopartículas de quitosano y extracto de Arándano sobre Colletotrichum fragariae en fresa. Rev. Iberoam. Tecnol. Postcosecha 2018, 19. [Google Scholar]
- Salgado Ramírez, D.A. Elaboración de Nanopartículas de Quitosano-Timol Mediante el Método Pulverización-Congelación en Nitrógeno Líquido, Evaluación de su Capacidad Antifúngica Frente a Micelio de Botrytis cinerea y Comparación con Nanopartículas Obtenidas por Gelificación Iónica. 2019. Available online: https://repositorio.uchile.cl/handle/2250/173568 (accessed on 20 August 2024).
- Lipsa, F.D.; Ursu, E.L.; Ursu, C.; Ulea, E.; Cazacu, A. Evaluation of the Antifungal Activity of Gold–Chitosan and Carbon Nanoparticles on Fusarium oxysporum. Agronomy 2020, 10, 1143. [Google Scholar] [CrossRef]
- Valenzuela-Ortiz, G.; Gaxiola-Camacho, S.M.; San-Martín-Hernández, C.; Martínez-Téllez, M.Á.; Aispuro-Hernández, E.; Lizardi-Mendoza, J.; Quintana-Obregón, E.A. Chitosan Sensitivity of Fungi Isolated from Mango (Mangifera indica L.) with Anthracnose. Molecules 2022, 27, 1244. [Google Scholar] [CrossRef]
- Sowjanya, N.T.; Dhivya, R.; Meenakshi, K.; Vedhanayakisri, K.A. Potential applications of chitosan nanoparticles as novel support in enzyme immobilization. Res. J. Eng. Technol. 2013, 4, 14. [Google Scholar]
- Caro-León, F.J.; López-Martínez, L.M.; Lizardi-Mendoza, J.; Argüelles-Monal, W.; Goycoolea-Valencia, F.M.; Carvajal-Millán, E.; López-Franco, Y.L. Preparation methods of chitosan nanoparticles: A review. Biotecnia 2019, 21, 13–25. [Google Scholar] [CrossRef]
- Jha, R.; Mayanovic, R.A. A review of the preparation, characterization, and applications of chitosan nanoparticles in nanomedicine. Nanomaterials 2023, 13, 1302. [Google Scholar] [CrossRef] [PubMed]
- Vallejo-Domínguez, D.; Rubio-Rosas, E.; Aguila-Almanza, E.; Hernández-Cocoletzi, H.; Ramos-Cassellis, M.E.; Luna-Guevara, M.L.; Rambabu, K.; Manickam, S.; Munawaroh, H.S.H.; Show, P.L. Ultrasound in the deproteinization process for chitin and chitosan production. Ultrason. Sonochem. 2021, 72, 105417. [Google Scholar] [CrossRef] [PubMed]
- Rivas, C.J.M.; Tarhini, M.; Badri, W.; Miladi, K.; Greige-Gerges, H.; Nazari, Q.A.; Rodríguez, S.A.G.; Román, R.Á.; Fessi, H.; Elaissari, A. Nanoprecipitation process: From encapsulation to drug delivery. Int. J. Pharm. 2017, 532, 66–81. [Google Scholar] [CrossRef]
- Bashir, S.M.; Ahmed Rather, G.; Patrício, A.; Haq, Z.; Sheikh, A.A.; Shah, M.Z.u.H.; Singh, H.; Khan, A.A.; Imtiyaz, S.; Ahmad, S.B.; et al. Chitosan nanoparticles: A versatile platform for biomedical applications. Materials 2022, 15, 6521. [Google Scholar] [CrossRef]
- El-Mohamedya, R.S.R.; Abd El-Aziz, M.E.; Kamel, S. Antifungal activity of chitosan nanoparticles against some plant pathogenic fungi in vitro. Agric. Eng. Int. CIGR J. 2019, 21, 201. Available online: https://cigrjournal.org/index.php/Ejounral/article/download/5425/3209/0 (accessed on 29 September 2024).
- Lopez-Moya, F.; Suarez-Fernandez, M.; Lopez-Llorca, L.V. Molecular mechanisms of chitosan interactions with fungi and plants. Int. J. Mol. Sci. 2019, 20, 332. [Google Scholar] [CrossRef]
- Velásquez, C.L.; Avelizapa, L.R. A Review on the Physicochemical and Biological Aspects of the Chitosan Antifungal Activity in Agricultural Applications. J. Res. Updates Polym. Sci. 2020, 9, 70–79. [Google Scholar] [CrossRef]
- Nasaj, M.; Chehelgerdi, M.; Asghari, B.; Ahmadieh-Yazdi, A.; Asgari, M.; Kabiri-Samani, S.; Sharifi, E.; Arabestani, M. Factors influencing the antimicrobial mechanism of chitosan action and its derivatives: A review. Int. J. Biol. Macromol. 2024, 277, 134321. Available online: https://www.sciencedirect.com/science/article/pii/S0141813024051262?casa_token=o7zXjj2RKdMAAAAA:8y9Pcg_KDWAhSkgZlUawaeEUB4gYaxQAIziQ6uFqF3-v43NCEn1vuwp_EwRTauaDMZE7uVdQ21jf (accessed on 29 September 2024). [CrossRef]
- Berthold, A.; Cremer, K.; Kreuter, J. Preparation and characterization of chitosan microspheres as drug carrier for prednisolone sodium phosphate as model for anti-inflammatory drugs. J. Control. Release 1996, 39, 17–25. [Google Scholar] [CrossRef]
- Lemes, I.G.; Vitón, T.M.; Jiménez, A.P. Actividad antifúngica de sales de quitosana in vitro sobre hongos causantes de enfermedades poscosecha en papaya (Carica papaya). Fitosanidad 2014, 18, 33–40. [Google Scholar]
- Ing, L.Y.; Zin, N.M.; Sarwar, A.; Katas, H. Antifungal activity of chitosan nanoparticles and correlation with their physical properties. Int. J. Biomater. 2012, 2012, 632698. [Google Scholar] [CrossRef] [PubMed]
- Arceo-Martínez, M.T.; Jiménez-Mejía, R.; Salgado-Garciglia, R.; Santoyo, G.; López-Meza, J.E.; Loeza-Lara, P.D. Efecto antifúngico in vitro E in vivo de quitosano sobre patógenos de fresa en postcosecha. Agrociencia 2019, 53, 1297–1311. [Google Scholar]
- Rivero, D.; Cruz, A.; Martínez, B.; Rodríguez, A.T.; Ramírez, M.A. Actividad antifúngica in vitro de las quitosanas k1 y sigma frente a Bipolaris oryzae (B. de Haan) Shoem. Rev. Prot. Veg. 2008, 23, 43–47. Available online: http://scielo.sld.cu/scielo.php?script=sci_arttext&pid=S1010-27522008000100008&lng=es&nrm=iso&tlng=en (accessed on 11 July 2024).
- Bagre, A.P.; Jain, K.; Jain, N.K. Alginate coated chitosan core shell nanoparticles for oral delivery of enoxaparin: In vitro and in vivo assessment. Int. J. Pharm. 2013, 456, 31–40. [Google Scholar] [CrossRef]
- Hiller, R.; Putterman, S.J.; Barber, B.P. Spectrum of synchronous picosecond sonoluminescence. Phys. Rev. Lett. 1992, 69, 1182–1184. [Google Scholar] [CrossRef]
- Vaezifar, S.; Razavi, S.; Golozar, M.A.; Karbasi, S.; Morshed, M.; Kamali, M. Effects of Some Parameters on Particle Size Distribution of Chitosan Nanoparticles Prepared by Ionic Gelation Method. J. Clust. Sci. 2013, 24, 891–903. [Google Scholar] [CrossRef]
- Tsai, M.L.; Bai, S.W.; Chen, R.H. Cavitation effects versus stretch effects resulted in different size and polydispersity of ionotropic gelation chitosan–sodium tripolyphosphate nanoparticle. Carbohydr. Polym. 2008, 71, 448–457. [Google Scholar] [CrossRef]
- Poznanski, P.; Hameed, A.; Orczyk, W. Chitosan and Chitosan Nanoparticles: Parameters Enhancing Antifungal Activity. Molecules 2023, 28, 2996. [Google Scholar] [CrossRef]
- Medina, E.L.; Gutiérrez, C.G.; Alaya, R.D.R. Nanotecnología y nanoencapsulación de plaguicidas. Ra Ximhai Rev. Científica Soc. Cult. Desarro. Sosten. 2010, 6, 63–67. Available online: https://www.redalyc.org/pdf/461/46112896009.pdf (accessed on 11 August 2024).
- Kheiri, A.; Jorf, S.A.M.; Malihipour, A.; Saremi, H.; Nikkhah, M. Synthesis and characterization of chitosan nanoparticles and their effect on Fusarium head blight and oxidative activity in wheat. Int. J. Biol. Macromol. 2017, 102, 526–538. [Google Scholar] [CrossRef] [PubMed]
- Rojo-Báez, I.; Álvarez-Rodríguez, B.; García-Estrada, R.S.; León-Félix, J.; Sañudo-Barajas, A.; Allende-Molar, R. Situación actual de Colletotrichums spp. en México: Taxonomía, caracterización, patogénesis y control. Rev. Mex. Fitopatol. 2017, 35, 549–570. [Google Scholar] [CrossRef]
- Weir, B.S.; Johnston, P.R.; Damm, U. The Colletotrichum gloeosporioides species complex. Stud. Mycol. 2012, 73, 115–180. [Google Scholar] [CrossRef]
- Contreras Hernández, C.A. Caracterización y Pruebas de Patogenicidad Cruzada Entre Aislamientos de Colletotrichum spp. Obtenidos de Frutos de Lulo (Solanum Quitoense Lam), Tomate de árbol (Solanum Betacea Sent), Granadilla (Passiflora ligularis Juss), Mango (Mangifera indica L.) y Tallos de Mora (Rubus Glaucus Benth) con Síntomas de Antracnosis. 2006. Available online: http://hdl.handle.net/10554/8253 (accessed on 20 August 2024).
- López-Zapata, S.P.; Castaño-Zapata, J.; López-Zapata, S.P.; Castaño-Zapata, J. In vitro effect of four fungicides on Colletotrichum gloeosporioides causing anthracnosis on the Red Globe grape variety. Rev. Acad. Colomb. Cienc. Exactas Fis. Nat. 2020, 44, 747–758. [Google Scholar] [CrossRef]
- Ayón Reyna, L.E.; Uriarte Gastelum, Y.G.; Camacho Díaz, B.H.; Tapia Maruri, D.; López López, M.E.; López Velázquez, J.G.; Vega Garcia, M.O. Antifungal Activity of a Chitosan and Mint Essential Oil Coating on the Development of Colletotrichum Gloeosporioides in Papaya Using Macroscopic and Microscopic Analysis. Food Bioprocess Technol. 2022, 15, 368–378. [Google Scholar] [CrossRef]
- Du, W.L.; Xu, Y.L.; Xu, Z.R.; Fan, C.L. Preparation, characterization and antibacterial properties against E. coli K88 of chitosan nanoparticle loaded copper ions. Nanotechnology 2008, 19, 085707. [Google Scholar] [CrossRef]
- Correa-Pacheco, Z.N.; Bautista-Baños, S.; Hernández-López, M.; Marquina-Valle, M.Á. Evaluación de nanoformulaciones en el desarrollo in vitro de hongos fitopatógenos. Rev. Mex. Fitopatol. 2018, 36, 457–467. [Google Scholar] [CrossRef]
- Barrera-Necha, L.L.; Correa-Pacheco, Z.N.; Bautista-Baños, S.; Hernández-López, M.; Jiménez, J.E.M.; Mejía, A.F.M. Synthesis and Characterization of Chitosan Nanoparticles Loaded Botanical Extracts with Antifungal Activity on Colletotrichum gloeosporioides and Alternaria species. Adv. Microbiol. 2018, 8, 286–296. [Google Scholar] [CrossRef]
- Chávez-Magdaleno, M.E.; Luque-Alcaraz, A.G.; Gutiérrez-Martínez, P.; Cortez-Rocha, M.O.; Burgos-Hernández, A.; Lizardi-Mendoza, J.; Plascencia-Jatomea, M. Effect of chitosan-pepper tree (Schinus molle) essential oil biocomposites on the growth kinetics, viability and membrane integrity of Colletotrichum gloeosporioides. Rev. Mex. Ing. Quim. 2018, 17, 29–45. [Google Scholar] [CrossRef]
- Honary, S.; Ghajar, K.; Khazaeli, P.; Shalchian, P. Preparation, Characterization and Antibacterial Properties of Silver-Chitosan Nanocomposites Using Different Molecular Weight Grades of Chitosan. Trop. J. Pharm. Res. 2011, 10, 69–74. [Google Scholar] [CrossRef]
- Chowdappa, P.; Gowda, S.; Chethana, C.S.; Madhura, S. Antifungal activity of chitosan-silver nanoparticle composite against Colletotrichum gloeosporioides associated with mango anthracnose. Afr. J. Microbiol. Res. 2014, 8, 1803–1812. [Google Scholar] [CrossRef]
- Wu, J.; Chang, J.; Liu, J.; Huang, J.; Song, Z.; Xie, X.; Wei, L.; Xu, J.; Huang, S.; Cheng, D.; et al. Chitosan-based nanopesticides enhanced anti-fungal activity against strawberry anthracnose as ‘sugar-coated bombs. Int. J. Biol. Macromol. 2023, 253, 126947. [Google Scholar] [CrossRef]
- Melo, N.F.C.B.; de Lima, M.A.B.; Stamford, T.L.M.; Galembeck, A.; Flores, M.A.; de Campos Takaki, G.M.; da Costa Medeiros, J.A.; Stamford-Arnaud, T.M.; Montenegro Stamford, T.C. In vivo and in vitro antifungal effect of fungal chitosan nanocomposite edible coating against strawberry phytopathogenic fungi. Int. J. Food Sci. Technol. 2020, 55, 3381–3391. [Google Scholar] [CrossRef]
- Dananjaya, S.H.S.; Erandani, W.K.C.U.; Kim, C.H.; Nikapitiya, C.; Lee, J.; De Zoysa, M. Comparative study on antifungal activities of chitosan nanoparticles and chitosan silver nano composites against Fusarium oxysporum species complex. Int. J. Biol. Macromol. 2017, 105, 478–488. [Google Scholar] [CrossRef]
- Li, X.-F.; Feng, X.-Q.; Yang, S.; Wang, T.-P.; Su, Z.-X. Effects of molecular weight and concentration of chitosan on antifungal activity against Aspergillus niger. Iran. Polym. J. 2008, 17, 843–852. Available online: https://sid.ir/paper/555011/en (accessed on 11 July 2024).
- Ma, Z.; Lim, L.Y. Uptake of Chitosan and Associated Insulin in Caco-2 Cell Monolayers: A Comparison between Chitosan Molecules and Chitosan Nanoparticles. Pharm. Res. 2003, 20, 1812–1819. [Google Scholar] [CrossRef]
- Correa-Pacheco, Z.N.; Bautista-Baños, S.; Valle-Marquina, M.Á.; Hernández-López, M. The Effect of Nanostructured Chitosan and Chitosan-thyme Essential Oil Coatings on Colletotrichum gloeosporioides Growth in vitro and on cv Hass Avocado and Fruit Quality. J. Phytopathol. 2017, 165, 297–305. [Google Scholar] [CrossRef]
- Correa-Pacheco, Z.N.; García-Paniagua, K.D.; Bautista-Baños, S.; Corona-Rangel, M.L. Efecto de nanorecubrimientos de quitosano-aceite esencial de tomillo sobre la calidad postcosecha en frutos de jitomate. Rev. Mex. Fitopatol. 2019, 37, 29–36. [Google Scholar] [CrossRef]

| Solution | Inhibition of Mycelial Growth by Day (%) | ||||
|---|---|---|---|---|---|
| 3 | 4 | 5 | 6 | 7 | |
| Control | 0 | 0 | 0 | 0 | 0 |
| A 0.25% ChNPS/PDA | 72 c | 74 c | 75 c | 76 c | 78 c |
| B 0.5% ChNPS/PDA | 92 ª | 93 a | 94 a | 95 a | 97 a |
| C 1% ChNPS/PDA | 82 b | 83 b | 86 b | 87 b | 89 b |
| D 0.25% ChNPS/PDA-H2O | 82 b | 86 b | 85 b | 83 b | 84 b |
| E 0.5% ChNPS/PDA-H2O | 79 b | 81 b | 82 b | 83 b | 86 b |
| F 1% ChNPS/PDA-H2O | 64 d | 65 d | 68.2 d | 68.7 d | 69 d |
| Treatments | Growth Speed of Colletotrichum gloeosporioides (cm/h) | ||||
|---|---|---|---|---|---|
| 3 | 4 | 5 | 6 | 7 | |
| Control | 0.040 a | 0.039 a | 0.040 a | 0.039 a | 0.038 a |
| A 0.25% ChNPS/PDA | 0.016 bc | 0.0125 bc | 0.0125 bc | 0.012 bc | 0.01 bc |
| B 0.5% ChNPS/PDA | 0.013 c | 0.0125 c | 0.01 c | 0.009 c | 0.008 c |
| C 1% ChNPS/PDA | 0.018 bc | 0.014 bc | 0.013 bc | 0.011 bc | 0.012 bc |
| D 0.25% ChNPS/PDA-H2O | 0.020 bc | 0.015 bc | 0.014 bc | 0.013 bc | 0.012 bc |
| E 0.5% ChNPS/PDA-H2O | 0.016 bc | 0.016 bc | 0.017 bc | 0.015 bc | 0.014 bc |
| F 1% ChNPS/PDA-H2O | 0.026 b | 0.023 b | 0.021 b | 0.02 b | 0.019 b |
Disclaimer/Publisher’s Note: The statements, opinions and data contained in all publications are solely those of the individual author(s) and contributor(s) and not of MDPI and/or the editor(s). MDPI and/or the editor(s) disclaim responsibility for any injury to people or property resulting from any ideas, methods, instructions or products referred to in the content. |
© 2024 by the authors. Licensee MDPI, Basel, Switzerland. This article is an open access article distributed under the terms and conditions of the Creative Commons Attribution (CC BY) license (https://creativecommons.org/licenses/by/4.0/).
Share and Cite
Solis Vizcaino, I.; Rubio Rosas, E.; Águila Almanza, E.; Marín Castro, M.; Hernández Cocoletzi, H. Ultrasonic Production of Chitosan Nanoparticles and Their Application Against Colletotrichum gloeosporioides Present in the Ataulfo Mango. Polymers 2024, 16, 3058. https://doi.org/10.3390/polym16213058
Solis Vizcaino I, Rubio Rosas E, Águila Almanza E, Marín Castro M, Hernández Cocoletzi H. Ultrasonic Production of Chitosan Nanoparticles and Their Application Against Colletotrichum gloeosporioides Present in the Ataulfo Mango. Polymers. 2024; 16(21):3058. https://doi.org/10.3390/polym16213058
Chicago/Turabian StyleSolis Vizcaino, Ivana, Efraín Rubio Rosas, Eva Águila Almanza, Marco Marín Castro, and Heriberto Hernández Cocoletzi. 2024. "Ultrasonic Production of Chitosan Nanoparticles and Their Application Against Colletotrichum gloeosporioides Present in the Ataulfo Mango" Polymers 16, no. 21: 3058. https://doi.org/10.3390/polym16213058
APA StyleSolis Vizcaino, I., Rubio Rosas, E., Águila Almanza, E., Marín Castro, M., & Hernández Cocoletzi, H. (2024). Ultrasonic Production of Chitosan Nanoparticles and Their Application Against Colletotrichum gloeosporioides Present in the Ataulfo Mango. Polymers, 16(21), 3058. https://doi.org/10.3390/polym16213058

